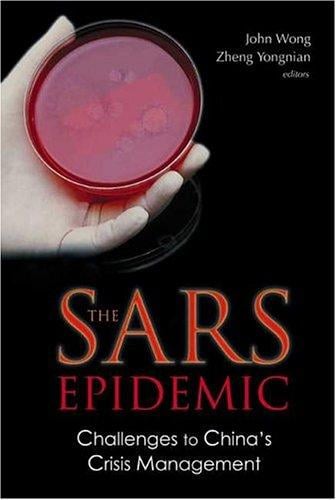
The SARS epidemic

Author Description
In the first half of 2003, severe acute respiratory syndrome (SARS) struck China (including Hong Kong), causing panic and claiming many lives. The unknown nature of SARS at that time also jolted the economic growth of China and Hong Kong, disrupted the social life of their citizens and created much stress and strain for their political systems and governance. Like other major crises, the management of the SARS crisis provides a good opportunity to examine the strengths and weaknesses of the political systems in China and Hong Kong. From the outset, scholars at the East Asian Institute followed closely the unfolding of the disease in China, particularly how each of the two societies coped with this random external shock. SARS may or may not recur in the near future, but the episode has offered a glimpse into the extent of resilience of the two societies, the quality of their political leadership, the effectiveness of their political and institutional mobilization, the crisis-management capability of their respective bureaucracies, and the viability of their governance systems.
Page Count:
226
Publication Date:
2004-01-01
ISBN-10:
9812389482
Health
Community Tags
Reader Comments
Share Your Thoughts
No comments yet. Be the first to share your thoughts!